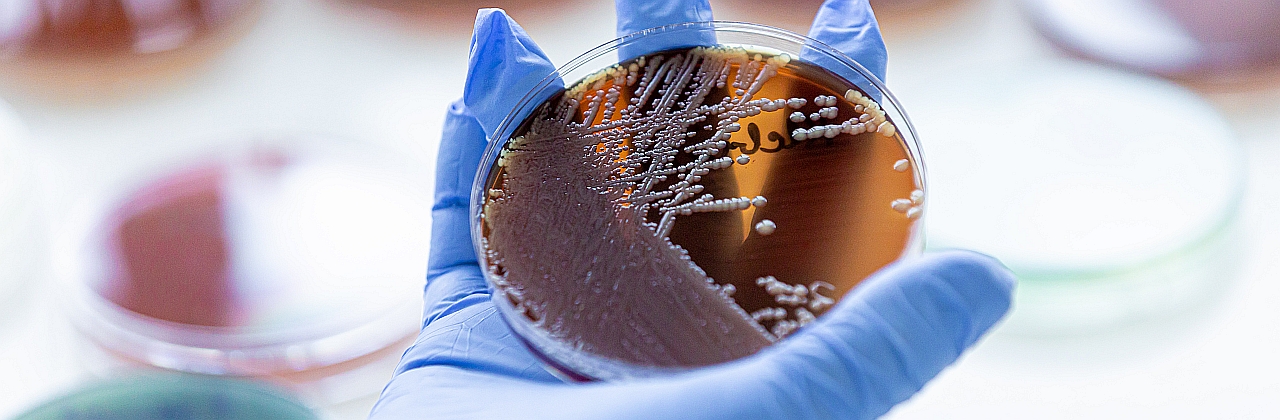

Bemutatkozás
Kedves Látogató! Szeretettel köszöntjük Önt intézetünk honlapján! A mikrobiológia a különböző mikroorganizmusok, kórokozók leírásával, jellemzésével foglalkozó tudomány. Az Intézet kutatói akkreditált PhD-témavezetők, az Intézet folyamatosan fogadja a mikrobiológiai iránt érdeklődőket a PhD-képzés valamint a TDK munka során. Munkatársaink a kutatómunka mellett meghatározó feladatokat látnak el a magyar nyelvű oktatás mellett az angol és német nyelvű …

Videók
Hasznos linkek
Elérhetőségek
Cím
1089 Budapest, Nagyvárad tér 4. X. emelet
1089 Budapest, Nagyvárad tér 4. X. emelet
Telefon
+36 1 210 2930 | +36 1 210 2940
+36 1 210 2930 | +36 1 210 2940
Fax
+36 1 210 2959
+36 1 210 2959
E-mail
titkarsag.mikro@med.semmelweis-univ.hu
titkarsag.mikro@med.semmelweis-univ.hu